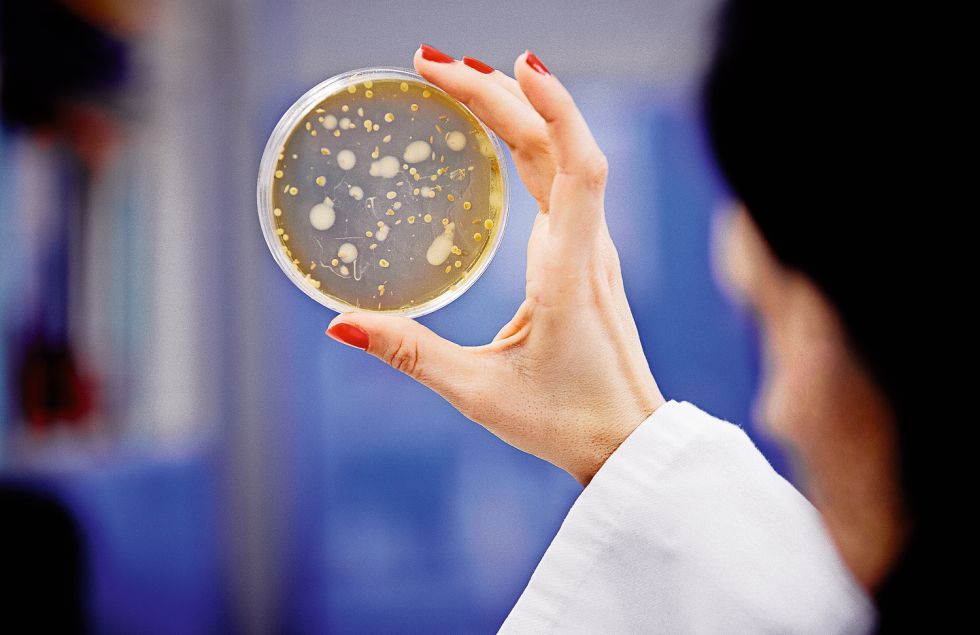

Els científics
són a un pas més a prop de saber per què els mosquits piquen més a unes
persones que a unes altres i apunten que aquest fet seria heretable. Perquè
segons un estudi que es coneix avui, la nostra genètica seria el factor
determinant en l'elecció de menú dels mosquits. La importància d'aquest
assumpte, en un món en el qual milions de persones moren per malalties
transmeses per aquests insectes, va molt més enllà, aquests mateixos científics
especulen si algunes persones estan desenvolupant en els seus gens una defensa
natural enfront de les picades.
L’experiment que
han dut a terme consistia en posar gairebé quaranta parelles de bessons exposats
a la picada dels mosquits. D'aquests, 18 eren bessons univitel·lins, els quals comparteixen el
100% dels seus gens, i 19 bessons bivitel·lins, per comprovar si la seva
genètica determinava el comportament dels mosquits. Els mosquits sí van mostrar
preferència entre algun de les bessons bivitel·lins, mentre que triaven amb el
mateix interès als bessons univitel·lins.
La conclusió és
molt clara, segons els científics de les universitats de Londres, Florida i
Nottingham que han realitzat l'estudi: "Els nostres resultats demostren un
component genètic subjacent al tipus d'olor humà, una diferència genètica que
és detectable pels mosquits a través de la nostra olor i que s'utilitza durant
la selecció de la persona ".
Estudis previs
havien mostrat que essencialment és l'olor corporal l'element clau que atrau
els mosquits cap a les persones. També se sabia que aquest atractiu pot variar
en funció d'altres factors: per exemple, beure cervesa sembla atreure més les
picades. Aquests insectes també se senten atrets per la temperatura corporal,
la suor, l'emissió de CO2, la roba de colors foscos, els bacteris de la pell i
les embarassades, per exemple, segons han mostrat altres treballs científics. No
obstant això, si els mosquits es trobessin a dues persones prenent cervesa en
una terrassa, en les mateixes condicions, seguirien tenint preferència per una
de les dues. Ara tenim una bona prova que és un regal dels seus pares, via
gens, el que provoca que alguns s'hagin de rascar més.
Font: http://elpais.com/elpais/2015/04/21/ciencia/1429613571_574034.html
Toni Galí Gimeno
1r batx. A